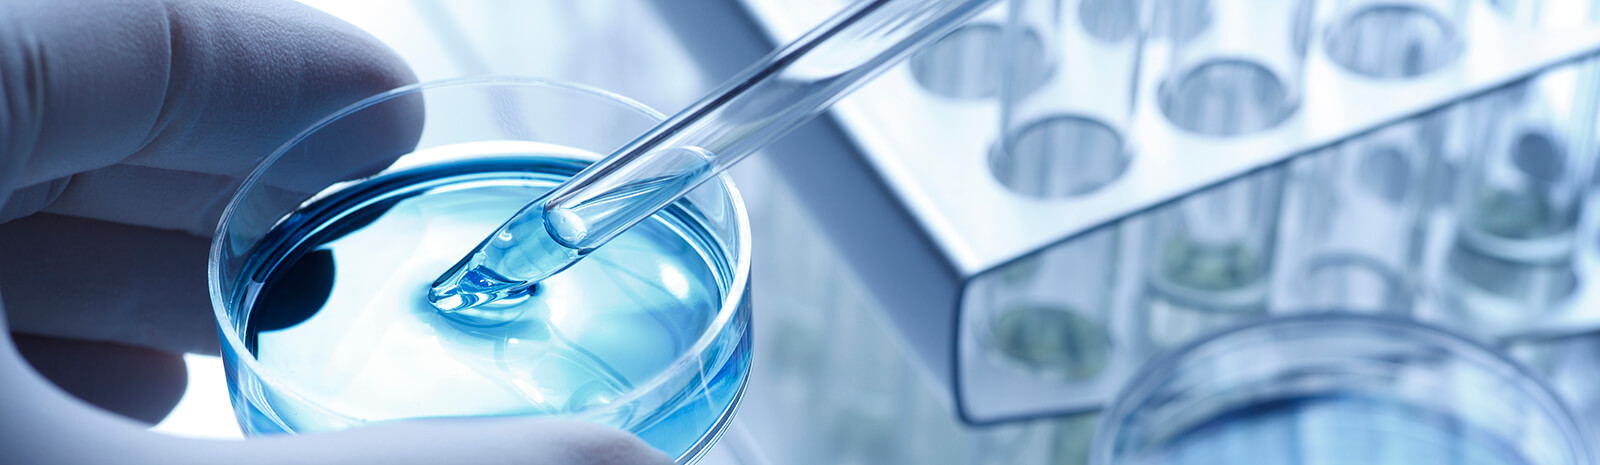

[Report] The State of Enterprise Agentic AI in 2026 - Agentic Reality Check: Hype or Not? Download Now

 Assistant
Assistant
Delivering innovative and life-changing treatments to patients with cancer and other severe, immune-inflammatory diseases is the company’s mission. They are committed to bringing transformative drugs to market but also ensuring that patients have access to these treatments.
With nearly 7,500 full-time employees (2,800 clinical) trying to answer questions and solve patient and clinical requirements, data was scattered across millions of files, a multitude of disparate systems and a slew of external sources.
Clinical employees experienced delays in:
The clinical query delays ultimately led to delays bringing new drugs to market.
The bold thinking which characterizes the company’s culture needed to be at the forefront to tackle the problem. Fuller, faster access to internal and external clinical trial information is paramount to helping the scientific team bring new treatments to market faster and at less cost.
A better, more capable information platform was the answer to solve both broad and deep problems. The Sinequa enabled solution helped speed and increase insights and ensure compliance with industry regulations.
The new solution enabled employees the ability to query millions of records from both internal and external sources for clinical, regulatory, quality and corporate content, from one interface.

Finding relevant, or duplicative adverse events used to take 5-7 minutes, can be done in 5 seconds with Sinequa.
Executive Director, Global Data, Information & Analytics
The Sinequa solution included identifying and quantifying the benefit of solving biotech specific business issues. The following results include the corresponding annual benefit:

…clinical trial scientists had to go to about 14 places…now have one place to look. There is productivity. There is cost-avoidance. We have 2000 drug safety operators who were querying multiple systems…what used to take 15 minutes is now done in 30 seconds.
Executive Director, Global Data, Information & Analytics